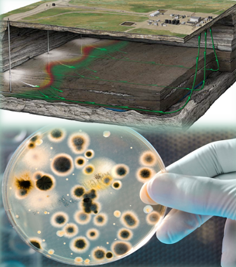

Карточка пользователя
Разработки и заказы
Cамоочищающийся фильтр в системе ППД

Cамоочищающийся фильтр в системе ППД

ТАТНЕФТЬ
Заказ на разработку | Категория: C
Cоздание интеллектуального цеха по ремонту насосно-компрессорных труб (НКТ) с автоматизированным и роботизированным производством

Разработать проект роботизированного цеха по ремонту НКТ, схему и алгоритм работы оборудования с автоматизацией технологических процессов ремонта НКТ с доведением количества технологического персонала на одной производственной линии в смену до минимального уровня.

ТАТНЕФТЬ
Заказ на разработку | Категория: B
Cокращение эксплуатационных и капитальных затрат для измерений загазованности на нефтедобывающих объектах

ОПИСАНИЕ
Инновационные технологические решения, обеспечивающие исключение участия персонала и сокращение эксплуатационных и капитальных затрат для измерений загазованности на нефтедобывающих объектах

ТАТНЕФТЬ
Заказ на разработку | Категория: B
Автоматизированное уравновешивание наземного привода СШН

Автоматизированное уравновешивание наземного привода СШН

ТАТНЕФТЬ
Заказ на разработку | Категория: C
Восстановление герметичности эксплуатационной колонны с помощью высокопрочного сложно модифицированного полимера

Восстановление герметичности эксплуатационной колонны с помощью высокопрочного сложно модифицированного полимера

ТАТНЕФТЬ
Заказ на разработку | Категория: B
Диагностика стеклопластиковых насосно- компрессорных труб и насосных штанг

Разработать и испытать технологии и оборудование для диагностирования
стеклопластиковых насосно-компрессорных труб и стеклопластиковых насосных штанг

ТАТНЕФТЬ
Заказ на разработку | Категория: B
Инновационные технологические решения, позволяющие снизить текущие затраты на профилактические мероприятия по очистке трубопроводов (в т.ч. СПТ) от АСПО и солей

ОПИСАНИЕ:
Инновационные технологические решения, позволяющие снизить текущие затраты на профилактические мероприятия по очистке трубопроводов (в т.ч. СПТ) от АСПО и солей.

ТАТНЕФТЬ
Заказ на разработку | Категория: B
Инновационные технологические решения, позволяющие снизить эксплуатационные затраты на капитальный, текущий ремонт трубопроводов и ликвидацию порывов.

ОПИСАНИЕ:
Инновационные технологические решения,
позволяющие снизить эксплуатационные затраты на капитальный, текущий ремонт трубопроводов и
ликвидацию порывов.

ТАТНЕФТЬ
Заказ на разработку | Категория: B
Инновационные технологические решения, обеспечивающие сокращение эксплуатационных и капитальных затрат для организации учета добытой продукции нефтедобывающих скважин.

Инновационные технологические решения, обеспечивающие сокращение эксплуатационных и капитальных затрат для организации учета добытой продукции нефтедобывающих скважин.

ТАТНЕФТЬ
Заказ на разработку | Категория: B
Инновационные технологические решения, позволяющие снизить текущие затраты на ликвидацию порывов и капитальный ремонт трубопроводов из стеклопластиковых труб (СПТ).

ОПИСАНИЕ:
Инновационные технологические решения, позволяющие снизить текущие затраты на ликвидацию порывов и капитальный ремонт трубопроводов из стеклопластиковых труб (СПТ).

ТАТНЕФТЬ
Заказ на разработку | Категория: B
Интегрированный программный комплекс «цифровой двойник трубопроводных систем» для предиктивного анализа по данным мониторинга выдаче рекомендаций для оптимальной эксплуатации трубопроводов и принятия

Интегрированный программный комплекс «цифровой двойник трубопроводных систем» для предиктивного анализа по данным мониторинга выдаче рекомендаций для оптимальной эксплуатации трубопроводов и принятия оперативных решений по режимным и аварийным данным

ТАТНЕФТЬ
Заказ на разработку | Категория: B
Исключение участия персонала и сокращение эксплуатационных и капитальных затрат для измерений обводненности продукции нефтедобывающих скважин

Инновационные технологические решения, обеспечивающие исключение участия персонала и сокращение эксплуатационных и капитальных затрат для измерений обводненности продукции нефтедобывающих скважин

ТАТНЕФТЬ
Заказ на разработку | Категория: B
Опережающее обводнение

Методы направленные на разработку и внедрение высокоэффективных водоизоляционных технологий

ТАТНЕФТЬ
Заказ на разработку | Категория: C
Повышение коэффициента охвата и вытеснения (тульский, бобриковский горизонты)

Поиск технологий и химических реагентов позволяющих увеличить коэффициент охвата и вытеснения.

ТАТНЕФТЬ
Заказ на разработку | Категория: C
Повышение коэффициента эксплуатации рентабельных скважин за счёт внедрения средств телемеханизации

Необходимы программно-аппаратные комплексы и интеллектуальные системы обработки информации направленные на оперативное информирование о фактах внеплановых остановок скважин, а также прогнозирования и предупреждение о возможных аварийных отказов.

ТАТНЕФТЬ
Заказ на разработку | Категория: B
Повышение эффективности методов увеличения нефтеотдачи

Методы, направленные на обеспечение рентабельной добычи и применение рентабельных методов повышения нефтеотдачи пластов

ТАТНЕФТЬ
Заказ на разработку | Категория: C
Поиск производителей запорной арматуры

Поиск производителей запорной арматуры

ТАТНЕФТЬ
Заказ на разработку | Категория: C
Поиск рентабельных технологий разработки участков

Поиск рентабельных технологий разработки участков с высоким риском преждевременного прорыва пластовой воды вследствие близости подстилающей воды, направленных на увеличение темпа разработки по башкирскому ярусу, серпуховскому, алексинскому горизонтам.

ТАТНЕФТЬ
Заказ на разработку | Категория: C
Поиск рентабельных технологий, направленных на удаление сероводорода из попутно добываемой воды

Снижение стоимости удаления сероводорода из попутно добываемой воды

ТАТНЕФТЬ
Заказ на разработку | Категория: C
Поиск способов сокращения удельного количества операций по ремонту и ревизии ГНО по отношению к фонду скважин

Необходимы технологии, позволяющие снизить операции по ремонту и ревизии глубинно-насосного оборудования

ТАТНЕФТЬ
Заказ на разработку | Категория: B
Поиск способов сокращения удельной продолжительности технологических операций по отношению к количеству ПРС с целью ГТМ

Необходимы технологии снижающие продолжительность технологических операций при ПРС

ТАТНЕФТЬ
Заказ на разработку | Категория: B
Поиск способов увеличения пористости и проницаемости в ПЗП за счёт удаления глинистых участков с целью увеличения темпа разработки по участку

Поиск способов увеличения пористости и проницаемости в ПЗП за счёт удаления глинистых участков с целью увеличения темпа разработки по
участку (терригенный девон - заглинизированные пласты)

ТАТНЕФТЬ
Заказ на разработку | Категория: C
Поиск технологий направленных на внедрение систем передачи данных с низкими эксплуатационными затратами для снижения затрат

Поиск решений для создания систем передачи данных, позволяющих минимизировать капитальные и эксплуатационные затраты.

ТАТНЕФТЬ
Заказ на разработку | Категория: B
Поиск технологий направленных на снижение капиталоёмкости процессов подготовки и сдачи нефти

Снижение стоимости капитальных затрат и капитального ремонта. Понижение металлоёмкости оборудования, применяемого при подготовки нефти и воды.

ТАТНЕФТЬ
Заказ на разработку | Категория: B
Поиск технологий направленных на снижение транспортных затрат на грузовые перевозки

Поиск технологий направленных на снижение транспортных затрат на грузовые перевозки и производство технологических операций с применением транспортных средств

ТАТНЕФТЬ
Заказ на разработку | Категория: B
Поиск технологий направленных на снижение удельного расхода электроэнергии на мех.подъём жидкости УЭЦН

Повышение КПД УЭЦН и его составных частей, снижение потерь связанных с подбором и эксплуатацией УЭЦН

ТАТНЕФТЬ
Заказ на разработку | Категория: B
Поиск технологий направленных на снижение эксплуатационных затрат и необходимости человеческого участия при эксплуатации контрольно- измерительных приборов и автоматики

Поиск решений для обеспечения достаточного уровня контроля и управляемости технологических процессов. Внедрение средств автоматизированных систем управления технологическим процессом для исключения ручного труда и человеческого фактора

ТАТНЕФТЬ
Заказ на разработку | Категория: B
Поиск технологий направленных на снижение эксплуатационных затрат на внедрение и применение средств измерений

Поиск решений для обновления существующего парка измерительного оборудования с учетом минимизации капитальных и эксплуатационных затрат

ТАТНЕФТЬ
Заказ на разработку | Категория: B
Поиск технологий направленных на снижение эксплуатационных затрат при эксплуатации АГЗУ "Спутник"

Поиск оборудования и технологий для модернизации существующего фонда АГЗУ «Спутник».

ТАТНЕФТЬ
Заказ на разработку | Категория: B
Поиск технологий направленных на снижение эксплуатационных затрат при эксплуатации полевого контрольно-измерительного прибора и автоматики, систем телемеханики

Поиск решений для внедрения эффективных средств автоматизации и телемеханизации. Развитие систем АСУТП для сокращения затрат по
основным процессам.

ТАТНЕФТЬ
Заказ на разработку | Категория: B
Поиск технологий направленных на сокращение удельного расхода электроэнергии на перекачку продукции скважин от ГЗНУ, ДНС

Разработать и испытать технологии обеспечивающие снижение удельного расхода электроэнергии на перекачку продукции скважин от ГЗНУ, ДНС

ТАТНЕФТЬ
Заказ на разработку | Категория: B
Поиск технологий повышения энергоэффективности системы ППД направленных на снижение удельного расхода электроэнергии на закачку жидкости в пласт

Повышение КПД насосов закачки, сокращение потерь на трение воды в водоводе, регулирование закачки с целью сокращения (исключения) дросселирования на КНС и штуцирования скважин.

ТАТНЕФТЬ
Заказ на разработку | Категория: B
Поиск технологий, направленных на не превышение удельного количества порывов промысловых нефтепроводов

Инновационные технологические решения, позволяющие снизить текущие затраты на капитальный ремонт трубопроводов, в т.ч. из СПТ

ТАТНЕФТЬ
Заказ на разработку | Категория: B
Поиск технологий, направленных на непревышение удельного количества порывов промысловых водоводов

Инновационные технологические решения, позволяющие снизить текущие затраты на ликвидацию порывов и текущий/капитальный ремонт трубопроводов.

ТАТНЕФТЬ
Заказ на разработку | Категория: B
Поиск технологий, направленных на повышение энергоэффективности установок катодной защиты

Инновационные технологические решения, позволяющие снизить текущие энергозатраты на ЭХЗ объектов добычи, трубопроводной транспортировки и подготовки продукции скважин ПАО "Татнефть"

ТАТНЕФТЬ
Заказ на разработку | Категория: B
Поиск технологий, направленных на снижение транспортных затрат на перевозку персонала.

Поиск технологий, направленных на снижение транспортных затрат на перевозку персонала.

ТАТНЕФТЬ
Заказ на разработку | Категория: B
Поиск технологий, направленных на снижение удельного количество восстановлений работоспособности ("реанимаций") трубопроводов, осложнённых АСПО

Инновационные технологические решения, позволяющие снизить текущие затраты на профилактические мероприятия по очистке трубопроводов от АСПО

ТАТНЕФТЬ
Заказ на разработку | Категория: B
Поиск технологий, направленных на снижение удельного расхода электроэнергии на общепромысловые нужды (за исключением объектов перекачки и СКЗ)

Повышение эффективности эксплуатации электрических приборов отопления и освещения, снижение потерь, связанных с подбором и эксплуатацией этих приборов

ТАТНЕФТЬ
Заказ на разработку | Категория: B
Поиск технологий, направленных на снижение удельных затрат по ПАО «ТН» на коррозионный мониторинг и обслуживание средств АКЗ РВС (емкостей)

Инновационные технологические решения, позволяющие снизить текущие затраты на коррозионный мониторинг от грунтовой (ГК) и внутренней коррозии РВС (емкостей), на содержание и обслуживание оборудования по ингибиторной защите кровли РВС и электрохимической защиты от внутренней (ВК) и грунтовой коррозии

ТАТНЕФТЬ
Заказ на разработку | Категория: B
Поиск технологий, направленных на снижение удельных затрат по ПАО «ТН» на коррозионный мониторинг и обслуживание средств АКЗ скважин

Инновационные технологические решения, позволяющие снизить текущие затраты на коррозионный мониторинг от грунтовой (ГК) и внутренней коррозии скважин, на содержание и обслуживание оборудования АКЗ скважин, электрохимической защиты от внутренней (ВК) и грунтовой коррозии скважин.

ТАТНЕФТЬ
Заказ на разработку | Категория: B
Поиск технологий, направленных на снижение удельных затрат по ПАО «ТН» на неразрушающий контроль, коррозионный мониторинг и обслуживание средств АКЗ трубопроводов

Инновационные технологические решения, позволяющие снизить текущие затраты на коррозионный мониторинг металлических трубопроводов от грунтовой (ГК) и внутренней коррозии, и обслуживание средств АКЗ трубопроводов от ГК (ТС без внутренней АКЗ с наружной изоляцией, трубопроводов с АКП) и ВК

ТАТНЕФТЬ
Заказ на разработку | Категория: B
Поиск технологий, направленных на сокращение удельных затрат на капитальный ремонт трубопроводов

Инновационные технологические решения, позволяющие снизить текущие затраты на капитальный ремонт трубопроводов, в т.ч. из стеклопластиковых труб.

ТАТНЕФТЬ
Заказ на разработку | Категория: B
Поиск технологий, направленных на сокращение удельных затрат на обработку добываемой продукции ингибиторами коррозии (бактерицидами) (при условии не превышения показателей коррозии НПО)

Инновационные технологические решения, позволяющие снизить текущие затраты на реагенты: ингибиторы коррозии и бактерициды

ТАТНЕФТЬ
Заказ на разработку | Категория: B
Поиск технологий, направленных на увеличение межремонтной наработки добывающего фонда скважин

Необходимы технологии и оборудование для повышения продолжительности срока эксплуатации нефтяных скважин

ТАТНЕФТЬ
Заказ на разработку | Категория: B
Поиск технологий, направленных на увеличение. межремонтной наработки нагнетательного фонда скважин

Необходимы технологии и оборудование для повышения продолжительности срока межремонтной эксплуатации нагнетательных скважин.

ТАТНЕФТЬ
Заказ на разработку | Категория: B
Поиск технологий, направленных на уменьшение удельного расхода электроэнергии на механический подъём жидкости установками штанговых глубинных насосов

Повышение коэффициента полезного действия установок штанговых глубинных насосов и их составных частей

ТАТНЕФТЬ
Заказ на разработку | Категория: B
Поиск эффективных технологий снижения вязкости нефти в пластовых условиях, направленных на увеличение темпа разработки по башкирскому ярусу, серпуховскому, алексинскому горизонтам.

Увеличение темпа разработки по башкирскому ярусу, серпуховскому, алексинскому горизонтам за счет применения методов увеличения нефтеотдачи(МУН) пластов

ТАТНЕФТЬ
Заказ на разработку | Категория: C
Поиск эффективных технологий снижения вязкости нефти в пластовых условиях, направленных на увеличение темпа разработки по турнейскому ярусу

ОПИСАНИЕ
Увеличение темпа разработки по турнейскому ярусу за счет применения методов увеличения нефтеотдачи (МУН) пластов

ТАТНЕФТЬ
Заказ на разработку | Категория: C
Предотвращение газопроявления при ремонте скважин

ОПИСАНИЕ
Необходимо блокировать поступление газа после вскрытия пласта.

ТАТНЕФТЬ
Заказ на разработку | Категория: C
Применение гидравлических приводов (ПШСНГ-120)

Инновационные технологические решения, обеспечивающие сокращение отказов гидравлических приводов ПШСНГ-120

ТАТНЕФТЬ
Заказ на разработку | Категория: C
Применение лазерной перфорации для эффективного вскрытия продуктивных пластов

Применение лазерной перфорации для эффективного вскрытия продуктивных пластов

ТАТНЕФТЬ
Заказ на разработку | Категория: B
Разработка и внедрение инновационных третичных методов увеличения нефтеотдачи, направленных на увеличение дебита

Методы направленные обеспечение рентабельной добычи и применение рентабельных методов повышения нефтеотдачи пластов

ТАТНЕФТЬ
Заказ на разработку | Категория: C
Разработка и изготовление композитных НКТ и муфт к ним с уменьшенной толщиной стенки

Разработка и изготовление композитных НКТ и муфт к ним с уменьшенной толщиной стенки из полимерных композитных материалов для 2-х лифтовой одновременно-раздельной закачки (труба в трубе) в скважинах малого диаметра

ТАТНЕФТЬ
Заказ на разработку | Категория: B
Разработка и изготовление стеклопластиковых (композитных) насосных штанг, стойких к кручению

Разработка и изготовление стеклопластиковых (композитных) насосных штанг, стойких к кручению

ТАТНЕФТЬ
Заказ на разработку | Категория: B
Разработка и изготовление стеклопластиковых (композитных) НКТ термостойких

предлагается решить проблему повышения термостойкости существующих стеклопластиковых НКТ для обеспечения возможности применения тепловых обработок (паром, горячей водой, нефтью и т.п.).

ТАТНЕФТЬ
Заказ на разработку | Категория: B
Разработка конструкции муфт с уменьшенной толщиной стенки для стеклопластиковых НКТ за счет применения углеволокна

Поиск технических решений, обеспечивающих возможность внедрения СП НКТ разных типоразмеров по аналогии со стальными НКТ. 2. Поиск технических решений, обеспечивающих возможность внедрения стеклопластиковых НКТ 73 мм на скважинах малого диаметра (114мм) без изменения внутреннего диаметра НКТ

ТАТНЕФТЬ
Заказ на разработку | Категория: B
Разработка Накопителя электроэнергии для преобразователя частоты

Разработка «Накопителя электроэнергии для преобразователя частоты», направленного на эффективное использование электроэнергии, вырабатываемой установкой штангового глубинного насоса (УШГН) при его работе в генераторном режиме

ТАТНЕФТЬ
Заказ на разработку | Категория: B
Разработка прибора для диагностирования стеклопластиковых НКТ и насосных штанг в процессе извлечения их из скважин

Поиск технологий и оборудования для диагностирования стеклопластиковых НКТ и стеклопластиковых насосных штанг

ТАТНЕФТЬ
Заказ на разработку | Категория: B
Разработка пьезоэлектрической насосной установки для индивидуальной закачки технологической жидкости в пласт

Повышение эффективности технологий по увеличению приемистости нагнетательных скважин

ТАТНЕФТЬ
Заказ на разработку | Категория: C
Разработка технологии ликвидации негерметичности НКТ отверждаемыми полимерными сферами (LockSphere)

Длительный процесс эксплуатации скважин под влиянием давления, коррозионно-активной среды и механических примесей нередко приводит к коррозионному нарушению герметичности насосно- компрессорных труб (НКТ). На сегодняшний день единственным способом ликвидации негерметичности НКТ является их замена с

ТАТНЕФТЬ
Заказ на разработку | Категория: C
Разработка технологии ликвидации негерметичности НКТ расплавом висмута Bi-Lock

Разработка технологии ликвидации негерметичности НКТ расплавом висмута Bi-Lock

ТАТНЕФТЬ
Заказ на разработку | Категория: C
Разработка технологий для диагностики и оценки состояния насосных штанг из полимерных композиционных материалов

В условиях ПАО «Татнефть» наблюдается необходимость в разработке и внедрении эффективных технологий и оборудования для входного и выходного контроля насосных штанг из полимерных композиционных материалов (СПНШ).

ТАТНЕФТЬ
Заказ на разработку | Категория: B
Разработка эффективных технологий интенсификации добычи нефти

Разработка эффективных технологий интенсификации добычи нефти

ТАТНЕФТЬ
Заказ на разработку | Категория: C
Разработка, изготовление и поставка мультипликатора давления для закачки воды в системе поддержания пластового давления

Разработка, изготовление и поставка мультипликатора давления для закачки воды в системе поддержания пластового давления

ТАТНЕФТЬ
Заказ на разработку | Категория: B
Разработку бесштангового скважинного насоса объёмного действия

С целью повышения энергоэффективности добычи продукции скважин, снижения затрат, связанных с обслуживанием верхнего привода и штанг, ликвидацией обрывов штанг, разработать бесштанговый скважинный насос объёмного действия.

ТАТНЕФТЬ
Заказ на разработку | Категория: B
Решения, направленные на чистку оборудования от донных отложений объектов подготовки нефти.

В резервуарах (РВС) установок подготовки нефти происходит накопление осадков влияющих на полезный объем РВС и качество хранимой продукции.

ТАТНЕФТЬ
Заказ на разработку | Категория: C
Роботизация процесса КРС

Поиск способов сокращения удельной продолжительности технологических операций по отношению к количеству ПРС.

ТАТНЕФТЬ
Заказ на разработку | Категория: B
Система обнаружения и локализации утечек на подводных участках трубопроводов на основе акустических (корреляционных) течеискателей

В ПАО «Татнефть» эксплуатируется часть нефтепроводов и водоводов, проходящих под водными объектами. Любая утечка на данных объектах может нанести ущерб окружающей среде и привести к экономическим потерям. Таким образом, обнаружение утечек и исключение их опасных последствий имеет важное значение.

ТАТНЕФТЬ
Заказ на разработку | Категория: B
Снижение затрат на обслуживание и ремонт оборудования по направлению ООНО

Снижение затрат на обслуживание и ремонт оборудования по направлению ООНО

ТАТНЕФТЬ
Заказ на разработку | Категория: B
Снижение обводнённости скважин

Методы направленные на разработку и внедрение высокоэффективных водоизоляционных технологий

ТАТНЕФТЬ
Заказ на разработку | Категория: C
Снижение средневзвешенного значения совокупной стоимости владения наземных приводов УШГН

Эксплуатация наземных приводов УШГН (СК, ПЦ, ГП) сопровождается большим количеством заявочных работ, выполняемых силами сервисной компании.
Так же имеет место быть значительное количество отказов оборудования.
Все это приводит к увеличению значения совокупной стоимости владения.

ТАТНЕФТЬ
Заказ на разработку | Категория: B
Снижение удельного количество восстановлений работоспособности ("реанимаций") трубопроводов, осложнённых АСПО и солями

Применение торпед с GPS-датчиком для выявления места сужения проходного сечения трубы для очистки отложений.

ТАТНЕФТЬ
Заказ на разработку | Категория: B
Снижение удельных затрат на сервисное обслуживание насосного оборудования ОВП

Снижение затрат на сервисное обслуживание, сокращение времени обслуживания, повышение качества обслуживания

ТАТНЕФТЬ
Заказ на разработку | Категория: B
Снижение удельных затрат на услуги по обслуживанию и ремонту УЭПН

Снижение удельных затрат на услуги по обслуживанию и ремонту УЭПН

ТАТНЕФТЬ
Заказ на разработку | Категория: B
Снижение эксплуатационных затрат на капитальный/текущий ремонт трубопроводов на традиционном фонде и СВН

Приборные методы неразрушающего выявления состояния трубопроводов без снятия изоляции в т.ч. ППУ изоляция.

ТАТНЕФТЬ
Заказ на разработку | Категория: B
Снижение эксплуатационных затрат на капитальный/текущий ремонт трубопроводов на традиционном фонде и СВН

Механизация процесса неразрушающего контроля при приемке сварочных стыков (поиск технологий).

ТАТНЕФТЬ
Заказ на разработку | Категория: B
Снижение эксплуатационных затрат на капитальный/текущий ремонт трубопроводов на традиционном фонде и СВН

Поиск инновационных материалов повышающих срок службы, снижающих металоемкость, стоимость владения.

ТАТНЕФТЬ
Заказ на разработку | Категория: B
Сокращение затрат на потребление пресной технической воды

Использование инновационных реагентов и применение инновационных систем фильтрации при подготовке пресной воды до норм котловой воды

ТАТНЕФТЬ
Заказ на разработку | Категория: B
Сокращение эксплуатационных и капитальных затрат для измерений уровней (взлив, пром.слои, подтоварная вода, донные отложения) жидкости в тех. процессах подготовки продукции нефтедобывающих скважин

Инновационные технологические решения, обеспечивающие сокращение эксплуатационных и капитальных затрат для измерений уровней (взлив, пром.слои, подтоварная вода, донные отложения) жидкости в тех. процессах подготовки продукции нефтедобывающих скважин

ТАТНЕФТЬ
Заказ на разработку | Категория: B
Техническое задание на разработку методики оценки потребности в техническом обслуживании (ТО) и капитальном ремонте (КР) станков-качалок

Необходимо снизить эксплуатационные затраты на техническое обслуживание станков-качалок при сохранении их работоспособности путем разработки методики определения оптимальной периодичности и объема технического обслуживания (ТО) и капитального ремонта (КР), включающей.

ТАТНЕФТЬ
Заказ на разработку | Категория: B
Технологии, направленные на повышение коэффициента вытеснения в карбонатных коллекторах

Методы, направленные на комплексное воздействие на пласт: одновременно увеличивать коэффициент охвата пласта заводнением и коэффициент вытеснения нефти в карбонатных коллекторах

ТАТНЕФТЬ
Заказ на разработку | Категория: C
Тизер унификация торцевых уплотнений насосов ЦНС

Унификация торцевых уплотнений насосов ЦНС

ТАТНЕФТЬ
Заказ на разработку | Категория: C
Эксплуатация наземного привода СШН с редуктором без применения масла.

Эксплуатация наземного привода СШН с редуктором без применения масла

ТАТНЕФТЬ
Заказ на разработку | Категория: C
Эксплуатация наземного СШН привода без редуктора

Эксплуатация наземного привода СШН без редуктора

ТАТНЕФТЬ
Заказ на разработку | Категория: C